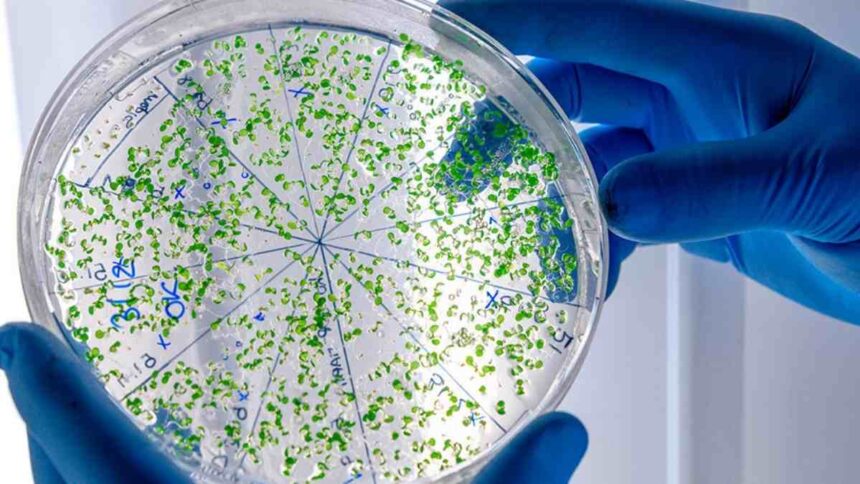

A confirmação de um caso de meningite meningocócica pela Secretaria de Estado da Saúde (SES), nesta quarta-feira, 11 de março, reforça a importância da imunização em todo o interior.
O paciente identificado com a doença está internado em Aracaju, mas a vigilância epidemiológica estadual já iniciou o monitoramento de pessoas que tiveram contato com o homem, que reside no interior da Bahia e circulou pela região. Conforme acompanhado anteriormente pelo portal, a cobertura vacinal em Lagarto tem sido prioridade nas campanhas recentes da prefeitura.
O quadro clínico do paciente é estável, porém, a gravidade da bactéria Neisseria meningitidis exige atenção redobrada dos moradores da região centro-sul.
Sintomas e Transmissão
A meningite é uma infecção das membranas que envolvem o cérebro. A transmissão ocorre de forma simples: através de gotículas de saliva, tosse ou espirro.
Os moradores de Lagarto devem ficar atentos a sintomas como febre alta repentina, dor de cabeça forte, rigidez no pescoço e vômitos. Caso algum desses sinais apareça, a recomendação é buscar imediatamente o Hospital Regional de Lagarto ou a unidade de saúde mais próxima.
Vacinação em Lagarto
A Secretaria Municipal de Saúde reforça que a vacina é a única forma eficaz de prevenir a doença. Em Lagarto, as doses estão disponíveis gratuitamente para o público-alvo nas Unidades Básicas de Saúde (UBS).
É fundamental que pais e responsáveis verifiquem a caderneta de vacinação das crianças e adolescentes, que são os grupos de maior risco para a forma meningocócica da doença.
Acompanhe outras notícias sobre: Saúde em Lagarto